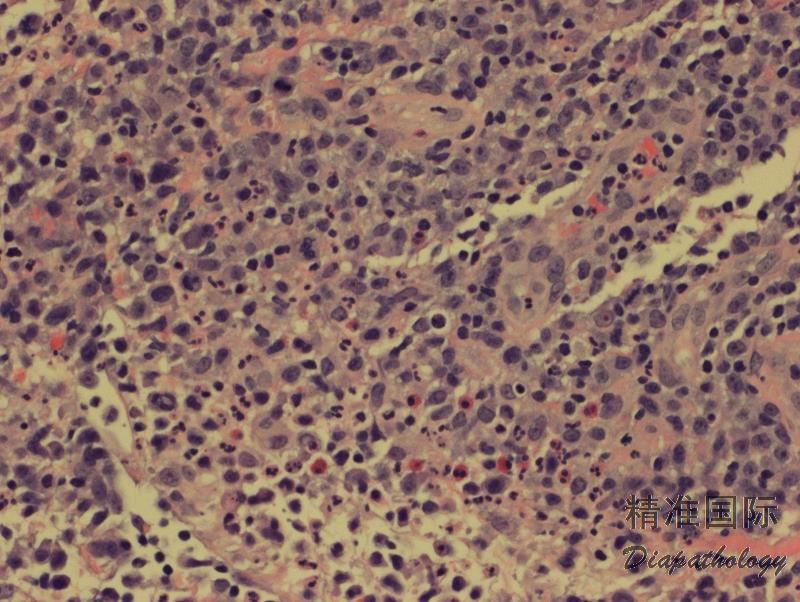
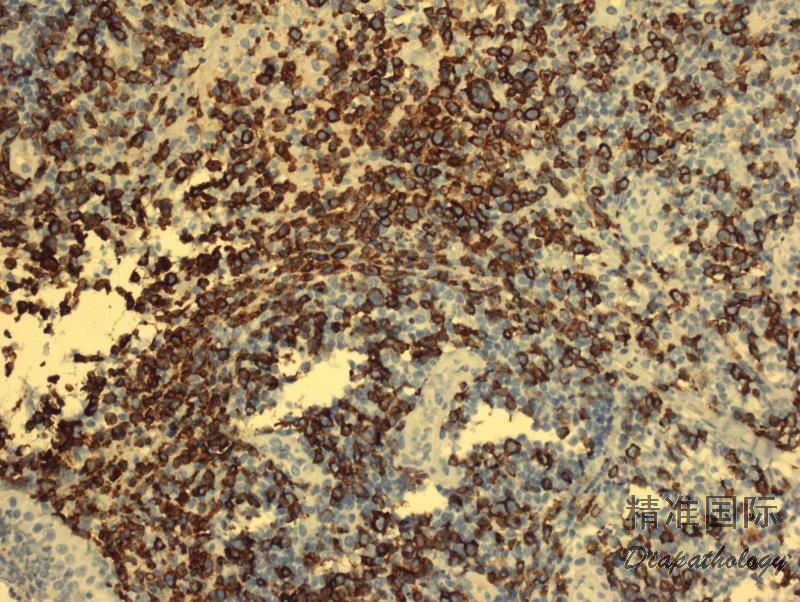

淋巴瘤样丘疹病
Lymphomatoid Papulosis, LyP
概述:
原发性皮肤 CD30 阳性 T 细胞淋巴组织增殖性疾病包括原发性皮肤间变性大细胞淋巴瘤(C-ALCL)、淋巴瘤样丘疹病(LyP)和交界性病变。这些疾病代表了一个连续的病变谱系,在形态、免疫和遗传学上常相互重叠。因此,临床表现和过程对确诊至关重要。有些病例,尽管经病理和临床综合研究,还是一时无法区分 C-ALCL 和 LyP(交界性病变)。 LyP 是一种慢性、周期性复发和自愈的皮肤疾病,其组织学表现为异形、间变样或 HRS 样大细胞及大量炎性背景细胞,但形态学变异很大,分为多种亚型。尽管组织学上提示 T 细胞淋巴瘤,但临床过程良性。
诊断要点:
主要见于成年人(中位年龄 45 岁),但儿童也可发病。限于皮肤,主要累及躯干和四肢。表现为多发(从数个到上百)皮肤丘疹或结节伴溃疡,病变常处于不同发展阶段,某一病变一般 3-12 周自行消失,留下表浅疤痕。病程长短不等(数月到几十年)。
低倍镜下,真皮病变区域多为楔形,但组织形态变异很大,部分是由于反映了病变的不同阶段。目前分为至少 6 种亚型。A 型:最常见(>80%)。散在的 CD30+异形单核、多核或 HRS 样大细胞混合于大量炎性背景细胞(小淋巴细胞、组织细胞、中性和嗜酸性粒细胞)。B 型:少见(<5%)。中小异型淋巴细胞(CD30+/-),含不规则和或脑回样核,呈现亲表皮侵润,与 MF 类似。C 型(约 10%):大异形细胞成片状侵润(CD30+),背景可有少量炎性细胞,此型与 C-ALCL 类似。 D 型(<5%):中小异形淋巴细胞强亲表皮性侵润,表达 CD8 和 CD30,类似原发性皮肤 CD8+侵袭性亲表皮细胞毒 T 细胞淋巴瘤。E 型(<5%):中小异形、多形性细胞(CD8+、CD30+)呈现血管中心性、血管破坏性浸润伴出血、坏死,临床表现为斑块结节病变,并很快形成溃疡,进而变成大的坏死结痂病灶。LyP 伴 6p25.3 重排(<5%):此型特征是有 DUSP22-IRF4 易位,组织学见中小异形脑回样核细胞(CD30 弱+)亲表皮浸润,伴中到大细胞(CD30 强+)真皮层浸润,类似 MF 大细胞转化。此外,还有其它罕见类型,如亲毛囊型、肉芽肿样型等。同一病例可以同时存在不同的组织学亚型。认识这些不同的亚型可以避免过度诊断为 T 细胞肿瘤。
免疫表型:大异形肿瘤细胞(A,C 型)表达 CD30 和细胞毒分子,常表达 CD4,但其它 T 细胞相关抗原常阴性。 B 型肿瘤细胞表达 CD3 和 CD4,但不表达 CD30 和 CD8。 D 和 E 型肿瘤细胞表达 CD30. CD3. CD8,不表达 CD4。DUSP22-IRF4 病例表达 CD8 或 CD4/CD8 双阴性,CD30 弱或强阳性。所有亚型都不表达 ALK,EMA 一般也阴性,有个 1 别报道表达 CD56。
大多数病例有 TCR 基因克隆性重排。

鉴别诊断:
间变大细胞淋巴瘤 (ALCL):包括原发性皮肤间变大细胞淋巴瘤(C-ALCL)和系统性间变大细胞淋巴瘤(ALCL)累及皮肤,主要需与 LyP C 型相鉴别。C-ALCL 常表现为单个结节或偶尔多个结节伴溃疡,组织形态单一(没有不同阶段的病变),几乎全是成片间变大细胞,累及真皮并倾向于延至皮下;继发性皮肤 ALCL 存在系统性 ALCL 的病史或证据,皮肤病变不会自行消失,肿瘤细胞常表达 EMA,部分病例 ALK+。需注意的是,C-ALCL 可与 LyP 相关,二者可先后或同时存在。
蕈样霉菌病 (MF):主要需与 B 型 LyP 相鉴别。楔形真皮侵润和同时存在不同病变阶段的大体及组织学形态支持 LyP; 而典型斑片、斑块和结节不伴中心坏死的病变发展过程则支持 MF。需注意的是,MF 可与 LyP 相关,二者可先后或同时存在。
原发性皮肤 CD8+ 侵袭性亲表皮细胞毒 T 细胞淋巴瘤 (Primary cutaneous CD8+ aggressive epidermotropic cytotoxic T-cell lymphoma):肿瘤细胞具亲表皮性且 CD8+, 主要需与 LyP D 型及 E 型相鉴别。临床表现为侵袭性过程,常侵犯全身皮肤,并累及内脏。组织学变异大,肿瘤细胞小到中等或中到大,侵润具高度的亲表皮性,同时呈现真皮带状或结节状侵润,常破坏皮肤附件结构并呈现血管中心性侵润。
原发性皮肤 γ/δT 细胞淋巴瘤 (Primary cutaneous γ/δT cell lymphoma):临床表现为侵袭性,肿瘤主要侵犯四肢可也累及全身皮肤和内脏。肿瘤细胞可侵润表皮、真皮或皮下,表达 CD3. CD56. CD2. TCRδ,不表达 CD4. CD8(少数+)、CD5. βF1。
外周 T 细胞淋巴瘤,非特指 (PTCL,NOS):累及皮肤时,表现为斑块或肿瘤结节。组织学表现肿瘤细胞主要弥漫或结节性侵犯真皮,形态大小不定,可混有少量炎性细胞。如皮肤同时存在典型的不同阶段病变(LyP)或患者有淋巴节 T 细胞淋巴瘤病史则有助鉴别。
经典霍奇金淋巴瘤 (CHL):包括系统性 CHL 累及皮肤和原发性皮肤 CHL,主要需与 LyP A 型相鉴别。CHL 常侵犯皮肤深层,典型的 HRS 细胞,CD30+,CD15+,也常 EBER+。病变不会自行消失。继发性皮肤 CHL 患者有系统性 CHL 病史。需注意的是,皮肤 CHL 发病,可与 LyP 相关,二者可先后或同时存在。
结外 NK/T 细胞淋巴瘤: 血管中心性浸润、血管破坏及出血坏死需与 LyP 的某些类型(特别是 E 型)相相似,其临床侵袭性、CD56+、EBER+有助鉴别。
反性性/炎症性皮肤病变 :需结合临床病史(如用药史,昆虫叮咬史)、病程进展、累及部位及范围、病变大体和组织形态等作综合判断。
预后:
预后好。需注意的是一些淋巴瘤如 MF、霍奇金淋巴瘤、皮肤间变大细胞淋巴瘤可以先于或继后于 LyP
